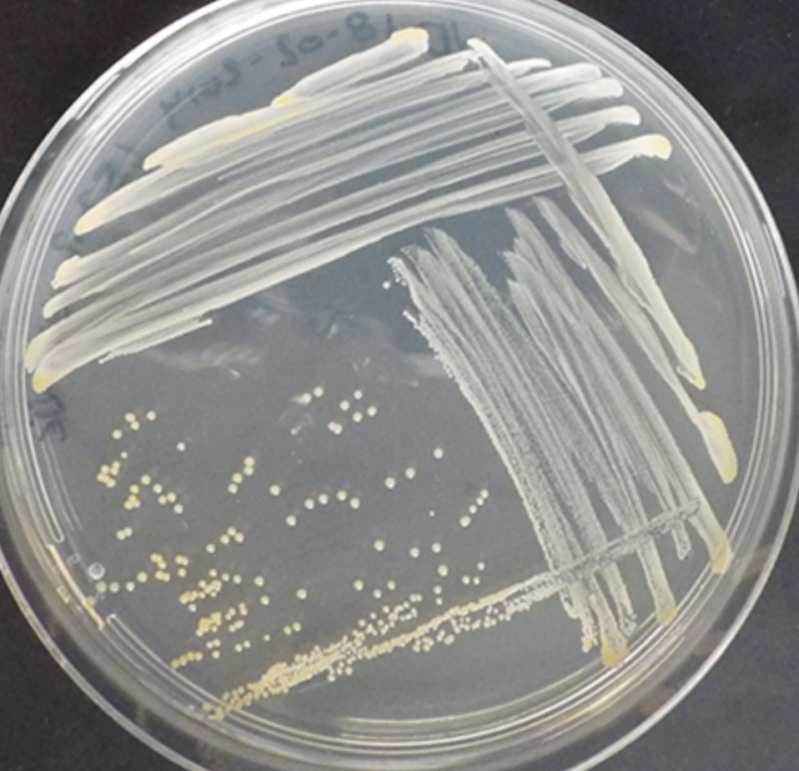

Voor bijzonder gelegenheden is een herinnering in zilver of goud extra waardevol
Pensioen, geboorte, trouwdag een mooie steen gevonden op een bijzondere plek

oorbellen met een verborgen kostganger, alleen voor de drager een bekend figuurtje

Er kwam de vraag of ik van de vingerafdrukken van 10 kleinkinderen een hanger kon maken. Dit is best een project. Allereerst de speciale siliconen in de juiste hoeveelheid en verhouding met de post opgestuurd. Inclusief voorbeeld beschrijving en mal. Hierna van de teruggestuurde siliconen een was afdruk gemaakt. En hiervan een bloem gemaakt. Op elk blaadje staan de initialen van het kleinkind. Dit naar de gieter gebracht die het gegoten heeft in zilver. Het resultaat is erg leuk geworden

Aspergillis


Thema Microbiologie schimmels



